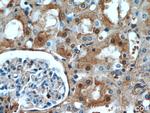
FXR1 Antibody in Immunohistochemistry (Paraffin) (IHC (P))

Search
Proteintech
FXR1 Polyclonal Antibody
{{$productOrderCtrl.translations['antibody.pdp.commerceCard.promotion.promotions']}}
{{$productOrderCtrl.translations['antibody.pdp.commerceCard.promotion.viewpromo']}}
{{$productOrderCtrl.translations['antibody.pdp.commerceCard.promotion.promocode']}}: {{promo.promoCode}} {{promo.promoTitle}} {{promo.promoDescription}}. {{$productOrderCtrl.translations['antibody.pdp.commerceCard.promotion.learnmore']}}
产品信息
13194-1-AP
种属反应
已发表种属
宿主/亚型
分类
类型
抗原
偶联物
形式
浓度
规格
纯化类型
保存液
内含物
保存条件
运输条件
产品详细信息
Immunogen sequence: MAELTVEVR GSNGAFYKGF IKDVHEDSLT VVFENNWQPE RQVPFNEVRL PPPPDIKKEI SEGDEVEVYS RANDQEPCGW WLAKVRMMKG EFYVIEYAAC DATYNEIVTF ERLRPVNQNK TVKKNTFFKC TVDVPEDLRE ACANENAHKD FKKAVGACRI FYHPETTQLM ILSASEATVK RVNILSDMHL RSIRTKLMLM SRNEEATKHL ECTKQLAAAF HEEFVVREDL MGLAIGTHGS NIQQARKVPG VTAIELDEDT GTFRIYGESA DAVKKARGFL EFVEDFIQVP RNLVGKVIGK NGKVIQEIVD KSGVVRVRIE GDNENKLPRE DGMVPFVFVG TKESIGNVQV LLEY (1-353 aa encoded by BC028983)
靶标信息
FXR1 is an RNA binding protein that interacts with the functionally-similar proteins FMR1 and FXR2. It may regulate intracellular transport and local transltion of certain mRNAs. These proteins shuttle between the nucleus and cytoplasm and associate with polyribosomes, predominantly with the 60S ribosomal subunit. FXR1 is required for embryonic and postnatal development of muscle tissue. Three transcript variants encoding different isoforms have been found for this gene.
仅用于科研。不用于诊断过程。未经明确授权不得转售。
生物信息学
蛋白别名: FMR1 autosomal homolog 1; FMR1 autosomal protein-like protein 1; fragile X mental retardation gene, autosomal homolog; fragile X mental retardation syndrome-related protein 1; fragile X mental retardation-related protein 1; fragile-X-related protein 1; FXR1P; hFXR1p; mFxr1p; RNA-binding protein FXR1; unnamed protein product
基因别名: 1110050J02Rik; 9530073J07Rik; AI851072; CMYO9A; CMYO9B; CMYP9A; CMYP9B; FXR1; Fxr1h; FXR1P; MYOPMIL; MYORIBF
UniProt ID: (Human) P51114, (Rat) Q5XI81, (Mouse) Q61584
Entrez Gene ID: (Human) 8087, (Rat) 361927, (Mouse) 14359